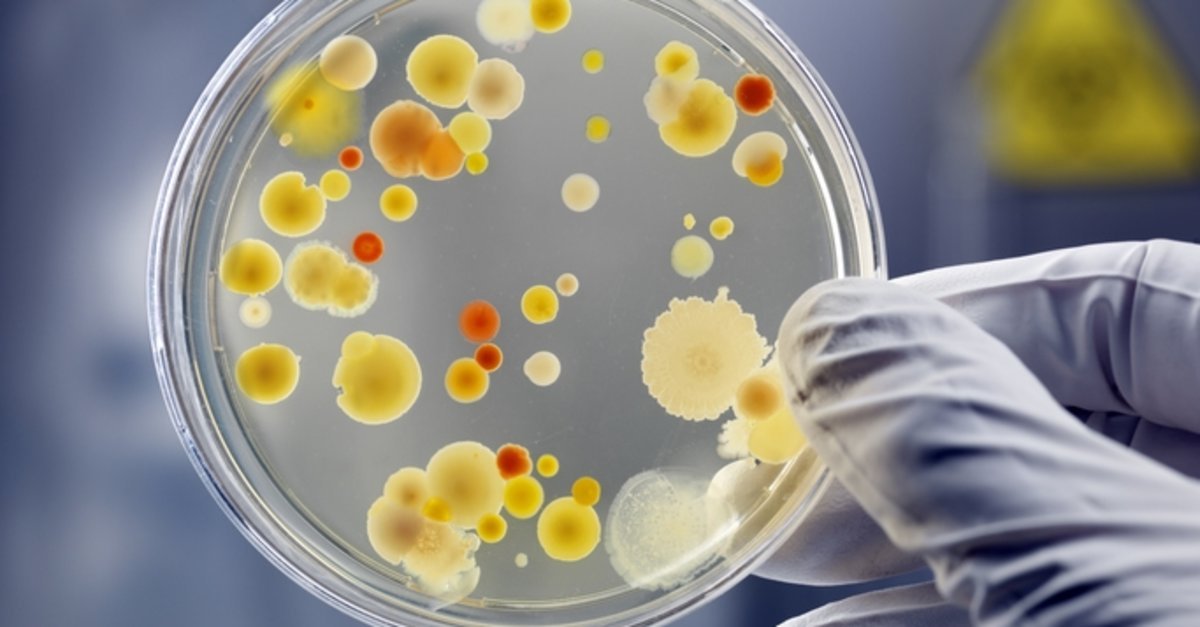
Bütüncül ve Fonksiyonel Tıp Hekimi Prof. Dr. Murat Hökelek konu

Bütüncül ve Fonksiyonel Tıp Hekimi Prof. Dr. Murat Hökelek konu hakkında bilgiler verdi.
İnsan vücudu, yiyecekleri sindirmekten hastalıklarla savaşmaya kadar, her şeye yardımcı olan faydalı bakterilerle doludur. Mikrobiyota adı verilen bu bakteriler, sağlıklı ve canlı kalmamıza yardımcı olur.
Peki bu bakterileri hastalıklarla savaşmamız veya belirtileri hafifletmemize yardımcı olması için kullanabilir miyiz? Araştırmalar mikrobiyotayı yenilemenin kanserden korunmayı sağlayabileceğini, kanser tedavilerinin etkinliğini artırabileceğini ve yan etkilerini azaltabileceğini göstermektedir. Ancak öncelikle mikrobiyotanın ne olduğu, neden önemli olduğu, kişilerin mikrobiyotasının kanser ve kanser tedavisindeki rolü hakkında bilgilenmek yararlı olacaktır.
Mikrobiyota nedir?
Mikrobiyota, bir canlı mikroorganizma topluluğudur. Vücudumuz, topluca mikrobiyota olarak adlandırılan trilyonlarca bakteri ve diğer organizmaları barındırmaktadır. Vücudumuzdaki kendi hücrelerimizden çok daha fazla bakteri ile birlikte yaşamaktayız. Bu dost bakterilerin toplam ağırlığı yaklaşık 1,5-2 kilogram kadardır.
Doğum esnasında bebekler ilk dost bakterileri anneden alırlar. Daha sonra insanlar yaşamları boyunca genetik, yaşam tarzı, yaş ve diğer faktörlere bağlı olarak değişen bir mikrobiyota oluşturmaya başlarlar. Mikrobiyotanın çoğu bağırsağımızda bulunur. Bu karmaşık mikrop topluluğu içerisinde binlerce tür vardır ve kişiden kişiye büyük farklılıklar gösterir. Bunlar bizi hastalıklara karşı korur, bağışıklık sistemimize ince ayarlar yapar, aldığımız besinleri nasıl kullanacağımızı belirler ve hücrelerimizin işlevlerini etkileyen bir dizi kimyasal madde üretir.
Sağlıklı ve gelişen bir mikrobiyomun nasıl oluştuğu hakkında bugünkü bilgiler sınırlıdır ve daha fazla araştırmalara ihtiyaç vardır. Ancak bazen mikrobiyotamızın dengesiz hale gelebileceği ve bu değişikliklerin başta kolon kanseri olmak üzere belirli hastalıklarla ilişkili olabileceği konusunda oldukça net bilgiler bulunmaktadır.
Araştırmalar mikrobiyota ve kanser hakkında ne gösteriyor?
Sağlıklı bir mikrobiyota diğer birçok kanser türünün gelişimini engellemektedir. Buna karşılık, kötü yapılanmış ve bozulmuş mikrobiyomun bazı kanser türlerinin gelişimini hızlandırabileceğini gösteren çalışmalar da mevcuttur. Mikrobiyota ve kanser çalışmaları devam etmektedir. Bilinenlerin bir kısmı deneysel çalışmalara dayanmaktadır. Örneğin, farelerin bağırsaklarındaki dost mikropların karaciğer tümörlerinin boyutunu azalttığını göstermiştir.
İnsanlarda gönüllülerle yapılan çalışmalarda, kanser ve dost mikroplar arasında daha fazla ilişki saptanmıştır. Örneğin, bazı araştırmalar, daha fazla çeşitliliğe sahip bir mikrobiyotanın cilt kanseri için immünoterapi tedavilerinin etkinliğini artırabileceğini bulmuştur. Diğer araştırmalar, bağırsaklarında çok çeşitli dost mikroplara sahip olan lösemi hastalarının hayatta kalma olasılığının daha yüksek olduğunu göstermiştir. Bu karmaşık ekosistemi düzenlemek, bir gün kanseri ve diğer hastalıkları önlememize veya tedavi etmemize yardımcı olabilir.
Yiyecekler, ilaçlar ve takviyeler mikrobiyotamızı nasıl etkiler?
Lif açısından zengin taze meyve ve sebzeler, besleyici gıdalar yemek, bağırsaklarınızda zaten yaşayan faydalı veya dost bakterileri beslemeye yardımcı olabilir. Bunlara prebiyotik gıdalar denir. Bağırsak mikrobiyomunuzu desteklemeye yardımcı olmak için faydalı bakteriler içeren bazı yiyecekleri tüketmek çok yararlıdır. Yoğurt, lahana turşusu ve kombucha gibi fermente gıdalar bu özelliklere sahiptir.
Yiyeceklerin yanı sıra, ilaçlar ve takviyeler probiyotik veya prebiyotik görevi görebilir. Sinbiyotikler, hem probiyotikleri hem de prebiyotikleri birleştiren takviyelerdir.
Kemoterapi ve ışın tedavisi gibi kanser tedavileri, bağırsak mikrobiyotasını bozabilir. Kanser tedavisi gören kişilerde probiyotikler dost mikropları yeniden dengelemeye yardımcı olabilir. Araştırmalar, probiyotiklerin akciğer kanseri için kemoterapi alan kişilerde ve kolon kanseri ameliyatı olan kişilerde ishali azaltabileceğini göstermiştir. Bunun özellikle kanser tedavisi sırasında hastalık seyrini olumlu etkilediği belirlenmiştir.
Probiyotikler, prebiyotikler veya sinbiyotikler de dahil olmak üzere herhangi bir takviye almayı düşünüyorsanız, doktorunuza danışarak kullanabilirsiniz.
Dışkı nakli mikrobiyotayı yenilemeye nasıl yardımcı olabilir?
Dışkı nakli, sağlıklı bir kişiden alınan ve daha sonra başka bir kişiye yerleştirilen dışkı örneğidir. Dışkı nakli birkaç şekilde olabilir; yutulan bir hap yoluyla, kolonoskopi sırasında yerleştirmeyle ya da burundan infüzyon ile uygulanabilmektedir. Klinik deneyler dışkı naklinin dost bakterileri yenilemeye yardımcı olduğunu göstermektedir.
Dışkı naklinin kanserli kişilerde bağırsak mikrobiyomunu nasıl yenileyebileceği ise halen araştırılmaktadır. Bazı kanser tedavilerinin genellikle, faydalı bağırsak bakterilerinin sayısını ve çeşitliliğini azaltmak da dahil olmak üzere bir takım yan etkileri vardır. Bu yan etkileri azaltmak amacıyla kanser kemoterapisi sırasında mikrobiyom tedavileri yararlı olabilmektedir.
Mikrobiyotanızı çeşitli ve sağlıklı tutmanın en iyi yolları hakkında bütüncül tıp hekimlerine danışmak ve uygun destekler almak sağlıklı bir yaşam açısından önemlidir.